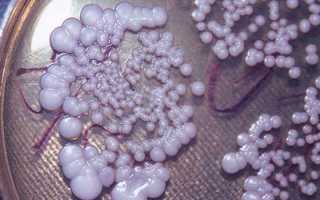
Как передается мышиная лихорадка — пути заражения и профилактика

Свое название редкое инфекционное заболевание получило благодаря переносчикам вируса – мышам. Патология характеризуется острым течением, может вызвать нарушения в работе почек, сердца, легких. Мужчины репродуктивного возраста болеют чаще других групп. Летальный исход возможен при несвоевременном лечении, сопутствующих заболеваниях.
Возбудитель мышиной лихорадки
Геморрагическая лихорадка с почечным синдромом (ГЛПС) является зооантропонозной инфекцией. Возбудителем является РНК-вирус рода Hantavirus. Он имеет спиралевидную или сферическую форму, долго сохраняется при низких температурах и погибает при 37 °С.
Для людей патогенными являются 4 серотипа – Seoul, Dobrava, Puumala, Hantaan. Вирусные агенты чаще размножаются в цитоплазме зараженных клеток почек, слюнных желез, печени. Хантавирус в теле погибшего носителя может прожить полгода. РНК-вирус чувствителен к средствам дезинфекции (хлорамин, раствор лизола), УФ-лучам и солнцу, но при этом устойчив к пенициллину.

Статьи по теме
- Профилактика мышиной лихорадки – как предотвратить заражение
- Симптомы мышиной лихорадки у детей – проявления на начальной стадии
- Симптомы мышиной лихорадки у мужчин – характерные проявления
Мнение врачей:
Мышиная лихорадка передается через контакт с инфицированными мышами или их мочой, калом. Воздушно-капельным путем инфицирование редко происходит. Важно соблюдать гигиену: избегать контакта с грызунами, убирать мусор, закрывать продукты. Профилактика включает дезинфекцию помещений, использование мышеловок. Вакцины для людей не существует, поэтому в случае симптомов (лихорадка, головная боль) важно обратиться к врачу. Своевременное лечение поможет избежать осложнений.

Пути передачи инфекции
Переносчиком инфекции являются грызуны – рыжая мышь-полевка, крысы, летучие мыши. Заражение происходит через мышиные экскременты. Вирус не передается от человека к человеку, только от инфицированных грызунов, которые представляют опасность на протяжении 2 лет.
Воздушно-пылевой путь
Мышиный грипп часто передается воздушно-пылевым путем, т.е. заразиться можно через вдыхаемую пыль. Частицы воздуха содержат маленькие фрагменты засушенного мышиного помета, которые могут вызвать лихорадку. Вирус попадает в организм через верхние дыхательные пути. Таким способом бактерия чаще передается людям, работающим в старых зданиях, зернохранилищах или на уборке зерновых.

Опыт других людей
Мышиная лихорадка – опасное заболевание, вызываемое вирусом, который передается через выделения мышей. Чаще всего заражение происходит через контакт с загрязненными местами или пищей. Люди, проживающие в загрязненных районах или работающие с грызунами, подвержены риску заражения. Для профилактики важно соблюдать гигиену, избегать контакта с мышами и обрабатывать помещения от грызунов. Лишний раз необходимо убеждаться в качестве пищи и воды, чтобы избежать возможного заражения. В случае появления симптомов заболевания, необходимо обратиться к врачу для своевременного лечения и предотвращения распространения инфекции.
Алиментарное заражение
Вирусные агенты попадают в организм и через употребление воды, плохо вымытых продуктов. Они содержат крысиный помет после контакта с грызунами. Инфекция передается фекально-оральным путем, т.е. через грязные руки с частицами помета в рот.
Инфицирование при прямом контакте
Заражение наступает при непосредственном контакте людей с фекалиями мышей. Для этого хватит и маленькой царапины на поверхности кожи. Прямой контакт с грызунами-носителями (живыми либо мертвыми) тоже приводит к появлению симптомов лихорадки, если у человека ослаблена иммунная система. Известны случаи контактного заражения людей после укусов насекомых, которые соприкасались с носителями-грызунами.

Профилактика мышиной болезни
Для предотвращения инфицирования существуют профилактические меры. Лихорадку можно предотвратить, если придерживаться рекомендаций:
- Соблюдать правила личной гигиены – мыть руки с мылом.
- Подвергать продукты термической обработке.
- Уничтожать грызунов в эпидемиологических районах.
- Мыть овощи, фрукты.
- Избегать соприкосновения пищи с почвой или водой.
- Не пить из ненадежных водоемов.
- Применять респиратор и перчатки при работе на сельскохозяйственных объектах.
- Проводить дератизацию производственных и жилых помещений.
- Тщательно упаковывать пищу, чтобы ограничить к ней доступ грызунов.
Видео
Внимание!
Информация, представленная в статье, носит ознакомительный характер. Материалы статьи не призывают к самостоятельному лечению. Только квалифицированный врач может поставить диагноз и дать рекомендации по лечению, исходя из индивидуальных особенностей конкретного пациента.
Статья обновлена: 21.10.2018
Частые вопросы
Как передается мышиная лихорадка от человека к человеку?
Между людьми вирус не передается. Специалистам известно несколько путей, как заразиться мышиной лихорадкой: Воздушно-пылевой – происходит вдыхание человеком мелких частичек мышиных фекалий. Контактный – вирус попадает в небольшие повреждения на коже при соприкосновении с инфицированными предметами.
Как происходит заражение мышиной лихорадкой?
В числе путей заражения: воздушно-капельный – вдыхание пыли, в которой содержатся мелкие частицы экскрементов, алиментарный – употребление воды, зараженной грызунами, контактный – при соприкосновении с кожей человека остатков продуктов жизнедеятельности и зараженного грунта.
Как защитить себя от мышиной лихорадки?
Перед началом уборки тщательно вымойте руки, наденьте маску и перчатки.Проветрите садовый домик, проведите в нем влажную уборку. … Герметично упакуйте и выкиньте все продукты, хранившиеся на даче.Во время уборки пейте только бутилированную воду, привезенную с собой.Ещё
Как долго живет вирус мышиной лихорадки?
Основным носителем служит полевая мышь. Вирус ГЛПС относительно устойчив во внешней среде при температуре от 4° до 20СС. В сыворотке крови, взятой у больных людей, сохраняется свыше 4 суток при 4°С. Инактивируется при температуре 50°С в течение 30 мин, при 0-4°С стабилен 12 час.
Полезные советы
СОВЕТ №1
Избегайте контакта с дикими грызунами, такими как мыши и крысы, чтобы предотвратить заражение мышиной лихорадкой.
СОВЕТ №2
Держите свои дома и окружающую территорию чистой и убранной, чтобы не привлекать грызунов к вашему жилищу.
СОВЕТ №3
Используйте средства индивидуальной защиты, такие как перчатки и маски, при работе в условиях, где возможно заражение мышиной лихорадкой.